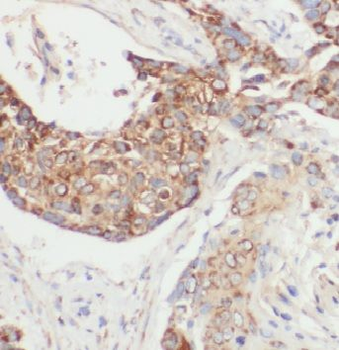
CTSH Antibody

You have no items in your shopping cart.
- CTSH Antibody [orb625453]Featured

ELISA, IF, IHC, WB
Human, Mouse, Rat
Rabbit
Polyclonal
Unconjugated
100 μg, 50 μg - Cathepsin H rabbit pAb Antibody [orb763903]Featured

ELISA, IF, IHC, WB
Human, Mouse, Rat
Polyclonal
Unconjugated
50 μl, 100 μl